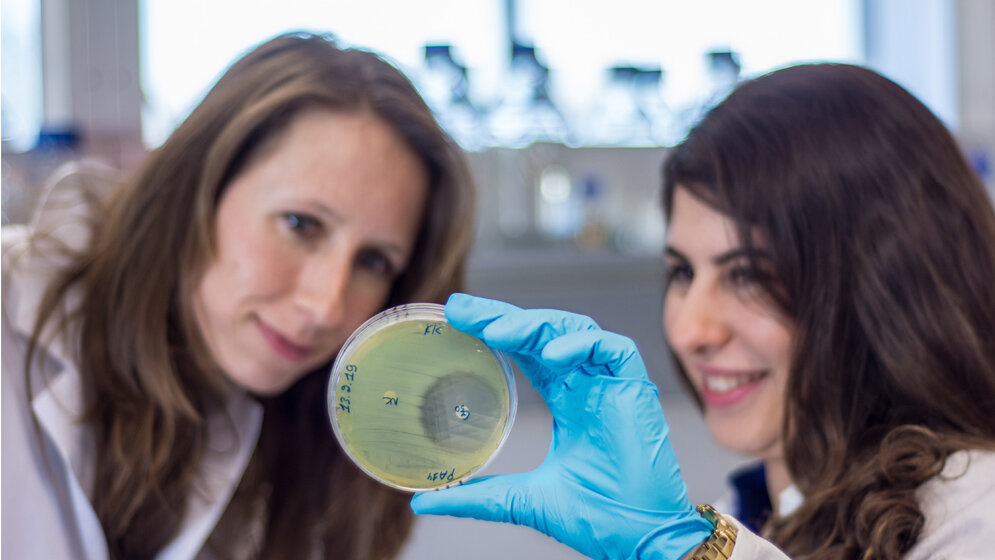
Krankheitserreger_Bacillus_thuringiensis_kann_in_ihrer_Naehe_nicht_gedeihen_Dr_Sabrina_Koehler.jpg Hemmwirkung der Pseudomonas-Bakterien

Vom Einzeller bis zum Menschen sind sämtliche Tiere und Pflanzen von Mikroorganismen besiedelt. Als sogenannte Wirtslebewesen beherbergen sie eine vielfältige Gemeinschaft von symbiotischen Kleinstlebewesen, das Mikrobiom, und bilden gemeinsam mit ihnen den sogenannten Metaorganismus. Das Mikrobiom rückt immer stärker ins Blickfeld der Wissenschaft, denn die darin ablaufenden Interaktionen von Körper und Mikroben üben einen bedeutenden Einfluss auf die Funktionen und die Gesundheit des Wirtslebewesens aus.
Rolle bei der Abwehr von Krankheitserregern
Wissenschaftlerinnen und Wissenschaftler erforschen im Sonderforschungsbereich (SFB) 1182 „Entstehen und Funktionieren von Metaorganismen“ an der Christian-Albrechts-Universität zu Kiel (CAU) diese komplexen Wechselwirkungen und schreiben den Mikroorganismen auch eine wichtige Rolle bei der Abwehr von Krankheitserregern zu. Dazu nutzen sie verschiedene sogenannte Modellorganismen, also Lebewesen, die sich in ihrem Zusammenspiel mit ihren bakteriellen Symbionten unter Laborbedingungen untersuchen lassen. Am Beispiel des Fadenwurms Caenorhabditis elegans hat nun ein Forschungsteam aus der CAU-Arbeitsgruppe Evolutionsökologie und Genetik die Funktion des natürlichen Darmmikrobioms untersucht. Dabei stellten sie fest, dass das natürliche Mikrobiom im Wurm offenbar eine wichtige Rolle bei der Abwehr von Infektionen übernimmt und bestimmte Bakterien einen deutlichen antimikrobiellen Effekt haben. Die Ergebnisse der Kieler Wissenschaftlerinnen und Wissenschaftler können künftig dabei helfen, die Funktionen des Darmmikrobioms insgesamt und insbesondere seine Effekte auf die Ansiedlung von Krankheitskeimen im Verdauungstrakt besser zu verstehen.
Direkter und indirekter Infektionsschutz
Den Grundstein für die aktuellen Forschungsergebnisse legte das Kieler Team vor wenigen Jahren, als es die erste systematische Analyse des natürlichen Fadenwurm-Mikrobioms vorlegte. Aus dieser Untersuchung ging eine genaue Kenntnis der Zusammensetzung und der dominierenden Arten dieser Bakterienbesiedlung hervor. Damals stellten die Forschenden die Hypothese auf, dass das natürliche Mikrobiom den Tieren einen evolutionären Vorteil verschafft, indem es sie zum Beispiel gegen Krankheitserreger schützen kann. Um diese bisher lediglich vermutete Funktion des Mikrobioms besser zu verstehen, beschäftigten sich die Forschenden nun mit einzelnen Bakterien aus der damaligen Studie. Sie untersuchten also, wie einzelne Bakterien auf bestimmte schädliche Keime wirken. Dabei machten sie zwei deutliche Wirkungsweisen aus.
Sechs Bakterienisolate an Abwehr von Infektionen beteiligt
„Einerseits konnten wir eine direkte Schutzwirkung bestimmter Bakterien gegen einen Krankheitserreger feststellen“, betont Dr. Katja Dierking, wissenschaftliche Mitarbeiterin in der Arbeitsgruppe Evolutionsökologie und Genetik an der CAU und Teilprojektleiterin im SFB 1182. „Bakterien der Gattung Pseudomonas hemmen das Wachstum des für den Wurm typischen Krankheitserregers Bacillus thuringiensis, wenn man beide in direkten Kontakt bringt“, so Dierking weiter. Außerdem zeigte sich bei der Untersuchung anderer Bakterien der Gattung Pseudomonas auch ein indirekter Effekt: Sie hemmen zwar nicht das Wachstum des Krankheitserregers, bewahren den Wurm aber trotzdem vor dessen schädlicher Wirkung. Insgesamt fanden die Forschenden sechs Bakterienisolate im natürlichen Mikrobiom, die an der Abwehr von Infektionen beteiligt sind. Zwei davon schützen den Wurm direkt vor dem Befall mit Krankheitskeimen, vier davon indirekt.
Produktion eines sogenannten zyklischen Lipopeptids
Eine weitere Besonderheit der neuen Kieler Studie ist, dass sie nicht nur die infektionshemmende Wirkung einzelner Bakterien des Fadenwurm-Mikrobioms beschreibt, sondern im nächsten Schritt auch einen zugrundeliegenden molekularen Mechanismus identifizieren konnte. Die Wissenschaftlerinnen und Wissenschaftler des Kieler SFB 1182 konnten in Zusammenarbeit mit Forschenden der Goethe Universität Frankfurt mittels genomischer und biochemischer Analysen ein antibakterielles Molekül identifizieren, das von den Mikrobiom-Bakterien, die Caenorhabditis elegans auf direkte Weise schützen, produziert wird. „Die Pseudomonas-Bakterien im Darm des Wurms produzieren ein sogenanntes zyklisches Lipopeptid“, erklärt Kohar Kissoyan, Erstautorin der Forschungsarbeit und Doktorandin in der Arbeitsgruppe Evolutionsökologie und Genetik. „Diese chemische Verbindung entfaltet eine direkte Hemmwirkung auf den Krankheitskeim und unterdrückt so sein weiteres Wachstum“, so Kissoyan weiter.
Kann man die neuen Erkenntnisse nutzen?
Die neuen Ergebnisse des Kieler Teams bilden eine wertvolle Grundlage für die weitere Erforschung der verschiedenen Funktionen des natürlichen Darmmikrobioms. Mit dem Fadenwurm Caenorhabditis elegans steht dafür in Kiel und in zahlreichen Forschungslaboren weltweit ein sehr weit verbreiteter und bestens untersuchter Modellorganismus zur Verfügung. Als nächstes wollen Dierking und ihr Forschungsteam den Wirkungsmechanismus des im Darmmikrobiom des Fadenwurms identifizierten antibakteriellen Moleküls im Detail nachvollziehen. Langfristiges Ziel des SFB 1182 ist es, auch die Wechselwirkungen der diversen Bakterien des Mikrobioms untereinander und mit dem Wirtsorganismus zu verstehen. In Zukunft, so hoffen die Kieler Forschenden, könne man durch Störungen des Darmmikrobioms verursachte Krankheiten mit der gezielten Gabe von sogenannten Probiotika, also bestimmten nützlichen Bakterienkulturen, möglicherweise erfolgreich therapieren. Diesem Ziel möchten sich die Kieler Wissenschaftlerinnen und Wissenschaftler in einer zweiten erfolgreichen Förderperiode weiter annähern. Aktuell bewirbt sich der 2016 gestartete Kieler Metaorganismus-Sonderforschungsbereich um die weitere Finanzierung durch die Deutsche Forschungsgemeinschaft (DFG) ab 2020. (idw, red)
Kohar Kissoyan, Moritz Drechsler, Eva-Lena Stange, Johannes Zimmermann, Christoph Kaleta, Helge Bode und Katja Dierking (2019): Natural C. elegans microbiota protects against infection via production of a cyclic lipopeptide of the viscosin group. Current Biology, Published on 28 February, 2019, DOI: doi.org/10.1016/j.cub.2019.01.050.
Artikel teilen